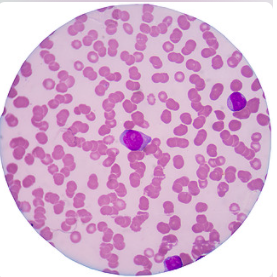

急性淋巴细胞白血病(ALL)是一种血液和骨髓癌,是美国和欧洲儿童最常见的癌症类型。这种类型的癌症发展迅速,会影响未成熟的细胞,但不会影响成熟的血细胞。
Erytech pharma公司宣布,FDA已经授予eryaspase快速通道指定,用于治疗对大肠杆菌(E. coli)衍生的聚乙二醇化天冬酰胺酶(pegylated asparaginase)过敏的急性淋巴细胞白血病(ALL)患者。
该批准是基于2期NOR-GRASPALL-2016试验(NCT03267030) 的数据。NOR-GRASPALL-2016试验是一项单臂研究,旨在研究eryaspase对聚乙二醇化天冬酰胺酶过敏的费城染色体(Ph)阴性ALL患者的药代动力学/药效学和安全性。Eryaspase通过静脉输注给药,剂量为150IU/kg,最多7剂;每2周最多给药4剂,每6周最多额外给药3剂。
在2020年美国血液学会年会(2020 ASH)上公布的试验结果表明,在55例接受eryaspase治疗的ALL患者中(每2周治疗一次),有54例患者的酶活性谷值水平维持在100U/L以上。Eryaspase疗法耐受性良好,大多数患者完成了整个预期疗程,每个患者接受治疗的中位数为5。
对聚乙二醇化天冬酰胺酶过敏的患者,维持足够的天冬酰胺酶治疗仍然是治疗ALL的一个重要目标。
Line Stensig Lynggaard博士表示:“目前,欧文氏菌衍生的天冬酰胺酶是聚乙二醇化天冬酰胺酶的替代治疗方案,全球供应短缺亟需新的替代治疗方案。我们的研究表明,每2周给予一次eryaspase治疗,不仅治疗方便,可以保持天冬酰胺酶活性水平,减少过敏反应,与化疗联合使用时,还具有良好的耐受性。因此,我们得出结论,对聚乙二醇化天冬酰胺酶过敏的ALL患者来说,eryaspase是一种不错的治疗选择。”
此外,Eryaspase还被作为一种潜在的系统治疗选择,用于胰腺癌患者的二线治疗,目前正在3期TRYbeCA-1试验(NCT03665441)中进行研究。此前,FDA和欧洲药品管理局授予了eryaspase孤儿药称号,用于治疗胰腺癌和急性淋巴细胞白血病。FDA还授予了eryaspase快速通道指定,用于胰腺癌的二线治疗。
天冬酰胺酶(asparaginase)是治疗急性淋巴细胞白血病(ALL)的主要化疗药物之一,在ALL的诱导及诱导后的治疗中起着重要作用。高达30%患者会对天冬酰胺酶产生超敏反应,eryaspase将成为一种最具吸引力的治疗选择,满足更多对天冬酰胺酶过敏的患者的治疗需求。